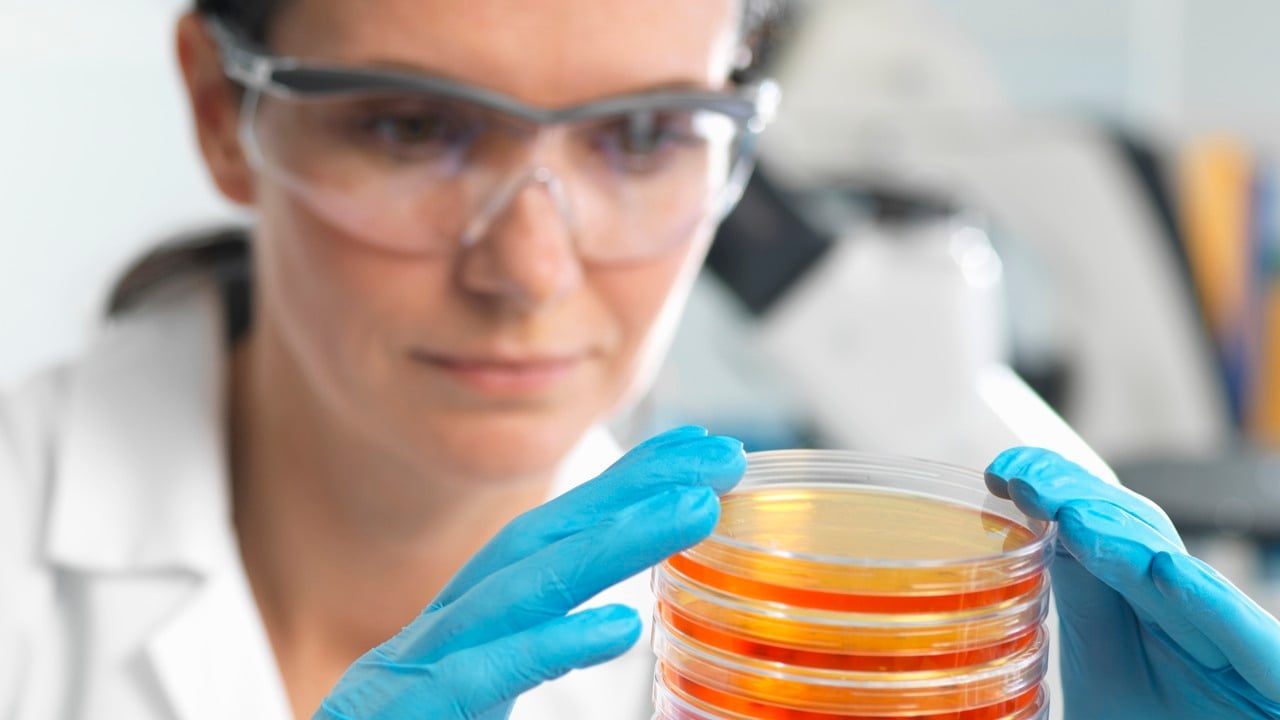
En kvinna med skyddsglasögon och skyddshandskar tittar på labbprover

Så utvecklas vården
Nya metoder och arbetssätt införs för att du ska få bästa möjliga vård idag och i framtiden. Här finns en beskrivning för dig som vill fördjupa dig i sjukvårdens olika utvecklingsområden.
Innehåll

Hälso- och sjukvården 2040
Region Stockholm planerar långsiktigt för invånarnas framtida behov. Därför har en utredning genomförts om utmaningar och möjligheter för vården inför år 2040.
Kunskapsstöd för jämlik vård
Sveriges regioner samarbetar i ett nationellt system för för att patienter ska få tillgång till en mer jämlik och kunskapsbaserad hälso- och sjukvård.
Nära vård
Region Stockholm arbetar kontinuerligt med att utveckla den nära vården i regionen.
Nationell högspecialiserad vård
För att patienter med sällsynta eller svårbehandlade diagnoser ska få bästa möjliga vård koncentreras högspecialiserad vård till ett antal vårdgivare i landet.
Regionalt utvecklingsansvar
I utvecklingsplanen för Stockholmsregionen ingår bland annat att säkerställa en tillgänglig, modern och god hälso- och sjukvård.
Forskning och innovation
Forskning och innovation har stor betydelse för att Region Stockholm ska kunna erbjuda invånarna en ännu bättre vård och högre livskvalitet.
Kunskapsutveckling om folkhälsa
Kunskapen om folkhälsa utvecklas bland annat genom det forskningsinriktade arbete som pågår vid olika centra inom Region Stockholm.